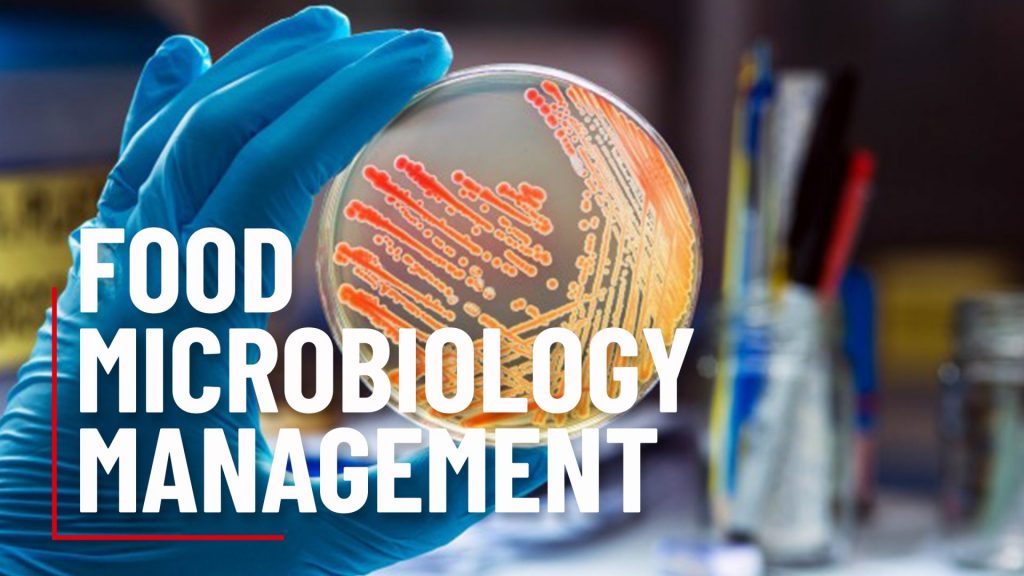

Food Microbiology Management
Application and Management of Food Microbiology Concepts
Food Fraud Risk Management

Managing the Risk of Food Fraud throughout your Interactions within the Food Sector
Food Compliance Culture

Implementing and Managing Food Compliance Culture Concepts
Food Borne Illness Prevention

Managing the Risk of Food Borne Illness
FDA Food Safety Modernization Act

FDA Food Safety Modernization Act
Equipment Design and Construction Standards

Maintaining Site Requirements for Equipment Design and Construction
Edible Cannabis Standards

Implementing and Managing Edible Cannabis Standards
Document and Data Control

Managing Document and Data Control as part of the Quality Management System
Customer Focus and Customer Complaint Management

Applying Customer Focus and Managing Customer Complaint Processes
Corrective Action and Preventative Action

Applying and Recording Corrective and Preventative Action including Root Cause Analysis